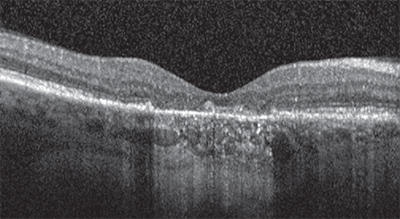

ABOUT THE AUTHORS | |
 | Dr. Sadda is a professor and director of Doheny Retina Service, Ophthalmic Imaging Unit and Doheny Image Reading Center (DIRC), Doheny Eye Institute, David Geffen School of Medicine, University of California, Los Angeles. He is is a consultant for Carl Zeiss Meditec, Optos, Allergan, Genentech, Alcon, Novartis and Roche. He receives research funding from Carl Zeiss Meditec, Optos, Allergan and Genentech. |
 | Dr. Abdelfattah is a senior postdoctoral research fellow at Doheny Eye Institute. He has no relationships to disclose. |
Recent studies have raised various questions about causes of atrophy in treated wet AMD. They include: Is it the natural progression of underlying dry AMD that drives the atrophy? Or is macular atrophy associated with the choroidal neovascularization (CNV) lesion? Or is macular atrophy associated with anti-VEGF therapy independent of CNV? And lastly, should what we know so far affect my management of patients?
Unfortunately, the studies and data that we have to date are really not designed to answer these crucial questions. In addition, as clinicians and researchers we struggle with the very definitions and identification of atrophy in the setting of wet AMD. It is important to remember that before anti-VEGF therapy, these patients were going on to develop large fibrotic disciform scars, and atrophy in this setting was not a major consideration. Certainly, no consensus exists with regards to the best diagnostic tools and methodology to detect and assess the progression of atrophy in this setting.
Despite these significant limitations, exploring what we know and don’t know at this point and considering how we should use this information in counseling our patients is a worthwhile exercise.
What We Know
 |
Multiple epidemiological studies and clinical trials have evaluated phenotypic risk factors for the development of late or advanced AMD, defined as the development of CNV or central demographic atrophy.2–5 These major risk factors include the presence of large drusen, larger drusen areas, subretinal drusenoid deposits and pigmentary alterations. These features have been incorporated into various scales to predict the risk of developing advanced AMD over time.6–9 These features, however, were based on and restricted by the types of analyses that were possible using flash color film photography.9–12
Flash color photographs also identified atrophy, basing its presence on a triad of features: depigmentation, increased visibility of choroidal blood vessels and sharply demarcated borders. Reliable identification of atrophy, however, depended on good quality imaging with excellent stereopsis. Subsequently, researchers have moved to using fundus autofluorescence (FAF) imaging to identify atrophy because it provides better contrast and is less dependent on image quality, but clinical trials of wet AMD have not used this tool thus far.
Identifying atrophy in the setting of neovascular AMD is at least one step more difficult due to the potential obscuring features of the CNV and associated exudative process. To most precisely study atrophy in this setting and also attempt to isolate the specific impact of anti-VEGF therapy on atrophy, one would focus on atrophic lesions that are separate from and non-adjacent to the CNV lesion. Unfortunately, the challenge to such an approach is that the CNV lesion may grow over time and eventually include the originally non-adjacent areas. Another challenge is that most studies define the CNV lesion based on a fluorescein angiogram (FA), whereas the true/full-extent of the lesion may be found to extend farther when one scrutinizes the optical coherence tomography (OCT) scans of these eyes.
Atrophy-Therapy Relationship
To better understand the characteristics and possible causes of vision loss in patients receiving anti-VEGF therapy, Philip Rosenfeld, MD, PhD, and colleagues retrospectively reviewed data from the Phase III ANCHOR and MARINA trials. They reported that 10 percent of study subjects who received monthly ranibizumab (Lucentis, Genentech) injections lost 15 or more letters of visual acuity (VA) over the course of 24 months.13 By comparison, 38 percent of patients in ANCHOR and 30 percent in MARINA gained at least 15 lines of vision in 24 months.In both trials, vision loss was associated with retinal pigment epithelium (RPE) abnormalities and growth of total lesion area. But these lesions didn’t look like typical advanced wet AMD; rather, they looked more like lesions that the authors speculated might evolve into geographic atrophy (GA). The reason photoreceptor loss occurs in patients who lose vision in the absence of active CNV or the more typical fibrotic scars seen in neovascular AMD is not yet known.
Several hypotheses propose that perhaps photoreceptor loss occurs in some treated lesions when the neovascularization serves an important function to sustain the diseased macula. Once the neovascularization is suppressed, the nutritional support is eliminated and the outer retina degenerates. This type of outer retinal degeneration may be similar to the typical disease progression observed in dry AMD in the absence of neovascularization. Another possibility is that VEGF serves an important neuroprotective role and suppression of VEGF eliminates this neuroprotection, which may result in vision loss in those patients who are more susceptible to the loss of VEGF.14,15
In the Comparison of Age-related Macular Degeneration Treatments Trials (CATT), which compared bevacizumab (Avastin, Genentech) and ranibizumab, investigators evaluated atrophy using color photographs and FA, but not the OCT.16 The found atrophy in 10.6 percent of subjects by the end of the first year, and in 18.3 percent by the end of second year. At two years of follow-up, the vast majority of patients with GA had extrafoveal GA (83 percent), whereas 32 patients (17 percent) had foveal GA.
One wonders, however, whether these extrafoveal GA patients would grow subfoveally if given enough time. According to the CATT trial, these characteristics were associated with increased risk for developing GA: visual acuity worse than 20/200, retinal angiomatous proliferation, GA in the fellow eye or intraretinal fluid at the foveal center at baseline. CATT showed that GA progressed faster in cases with classic CNV, GA in the fellow eye, ranibizumab therapy, non-subfoveal CNV, greater distance from foveal center and epiretinal membrane.
What Other Studies Tell Us
The Inhibition of VEGF in Age-related choroidal Neovascularization (IVAN) trial based assessment on evaluation of color photographs, FA and OCT.17 The difference in rates of atrophy between bevacizumab and ranibizumab was not statistically significant while similar to CATT. Continuous therapy caused more statistically significant atrophy than as needed therapyThe HARBOR study retrospectively regraded FA and color fundus photography data for the presence of atrophy.18 HARBOR investigators defined atrophy as well-defined areas of depigmentation with visible, increased choroidal vessels (a minimum of 250 µm) corresponding to flat areas of well-demarcated staining on FA. They did not include cases of atrophy with RPE tears. The HARBOR reading center investigators attempted to distinguish whether the atrophy was non-adjacent to the lesion. They included all atrophy immediately within, adjacent to and non-adjacent to CNV lesions. Their results, based on the inclusive definition, were the most comparable to CATT and IVAN studies.
Among study eyes with no detectable atrophy at baseline, CATT showed a 20 percent rate of atrophy in ranibizumab-treated eyes by month 14. In the IVAN trial, this rate was 28 percent and in HARBOR, 29 percent.
Regarding visual outcomes, patients with baseline macular atrophy gained 6.7 ETDRS letters versus 9.1 letters for those without atrophy. Important to note is that in the MARINA study, untreated control patients lost 14.9 ETDRS letters after 24 months from baseline.19
In HARBOR, eyes with and without concurrent atrophy had similar best-corrected visual acuity at each visit. Eyes that had intraretinal cysts or atrophy in the fellow eye at baseline were at higher risk of developing macular atrophy (MA). Interestingly, eyes with subretinal fluid (SRF) at baseline were at lower risk for developing MA. When looking at individual time points, less atrophy was detected in eyes with concurrent SRF, but patients with SRF were being treated per protocol in HARBOR to achieve the observed visual outcomes.
Higher doses of ranibizumab were not associated with an increased risk of MA, while monthly treatments (particularly at the FDA-cleared 0.5-mg dose) were associated with a higher risk of MA compared with as-needed therapy.
When considering the results of these studies, one must consider their limitations. The HARBOR analysis, for example, was a post-hoc retrospective assessment. While the plan to look for atrophy was pre-specified in CATT and IVAN, it is not clear if the study design pre-specified whether the details of how the cases would be graded and atrophy would be assessed. In addition, CATT re-assessed the presence and growth of atrophy multiple times, reflecting the difficulty of assessing atrophy in the setting of wet AMD using color photos and FA.
Importance Of Fundus Autofluorescence Imaging
All of these studies may benefit from a re-assessment of atrophy based on eventual consensus definitions and a multimodal approach that integrates information from all modalities. Even so, all of these studies lack FAF, which may prove to be a key modality for evaluating GA.The SEVEN-UP study used FAF in a small subset of 69 patients from the original MARINA and ANCHOR trials who received two years of monthly ranibizumab during the original trials and then were willing to come back seven years later after they started therapy.16 The sobering observation from this limited cohort was that, on average, patients went on to lose vision to a degree that left them worse off than their entry vision into MARINA and ANCHOR.
|
To summarize what we know: We know that patients with wet AMD can go on to lose vision over time and atrophy can be an important cause of this. We know that atrophy can occur in spite of anti-VEGF therapy. We know that the consistent risk factors for atrophy include the presence of intraretinal fluid and atrophy in the fellow eye. Continuous monthly therapy also appears to be associated with a higher rate of atrophy at least at two years.
Interestingly, subretinal fluid seems to be associated with a lower risk of atrophy. However, patients with subretinal fluid were still being treated in these studies to achieve the observed outcomes. We know that despite development of atrophy, patients still gain vision through at least 24 months, and we know from history that untreated patients lose considerable vision.
What We Don’t Know
Despite all of this information, we still don’t know if anti-VEGF therapy actually influences the development of atrophy in neovascular AMD. We also don’t know if the patients who had visual improvement despite the development of atrophy would eventually go on to lose vision over time. We don’t know if patients who are treated with the treat-and-extend regimen would develop rates of atrophy similar to monthly or as-needed (p.r.n.) therapy or somewhere in between. We also don’t know if we are detecting atrophy properly with the best definitions and methodology.So What Should We Do With What We Do Know?
Given that none of these studies was designed to address the question of whether anti-VEGF therapy has an impact on development of atrophy, the observations so far really should not drive changes in how we treat patients. For example, leaving a patient with active disease untreated for fear of atrophy would appear to be unwarranted, and potentially harmful.The data do suggest, however, that we should counsel patients that treating their wet AMD may not stop progression of their underlying dry AMD, and that they are still at risk for losing vision in the long term. Because the visual outcomes for p.r.n. and monthly therapy are similar, the observation of more atrophy with monthly therapy may lean one toward using a p.r.n. strategy until better data are available. RS
References
1. Ferris FL, Wilkinson CP, Bird A, et al. Clinical classification of age-related macular degeneration. Ophthalmology 2013;120:844-851.
2. Pascolini D, Mariotti SP. Global estimates of visual impairment: 2010. Br. J. Ophthalmol. 2012;96:614-618.
3. Friedman DS, O’Colmain BJ, Muñoz B, et al. Prevalence of age-related macular degeneration in the United States. Arch. Ophthalmol. 2004;122:564-72.
4. Rein DB, Wittenborn JS, Zhang X, Honeycutt AA, Lesesne SB, Saaddine J. Forecasting age-related macular degeneration through the year 2050: the potential impact of new treatments. Arch. Ophthalmol. 2009;127:533-540.
5. Bird AC, Bressler NM, Bressler SB, et al. An international classification and grading system for age-related maculopathy and age-related macular degeneration. The International ARM Epidemiological Study Group. Surv. Ophthalmol. 39:367-374. Available at: http://www.ncbi.nlm.nih.gov/pubmed/7604360. Accessed March 17, 2015.
6. Kawasaki R, Yasuda M, Song SJ, et al. The prevalence of age-related macular degeneration in Asians: a systematic review and meta-analysis. Ophthalmology 2010;117:921-927.
7. Krishnan T, Ravindran RD, Murthy GVS, et al. Prevalence of early and late age-related macular degeneration in India: the INDEYE study. Invest. Ophthalmol. Vis. Sci. 2010;51:701-707.
8. Klein R, Chou C-F, Klein BEK, Zhang X, Meuer SM, Saaddine JB. Prevalence of age-related macular degeneration in the US population. Arch. Ophthalmol. 2011;129:75-80.
9. Bressler SB, Maguire MG, Bressler NM, Fine SL. Relationship of drusen and abnormalities of the retinal pigment epithelium to the prognosis of neovascular macular degeneration. The Macular Photocoagulation Study Group. Arch. Ophthalmol. 1990;108:1442-1447. Available at: http://www.ncbi.nlm.nih.gov/pubmed/1699513. Accessed March 17, 2015.
10. Pauleikhoff D, Barondes MJ, Minassian D, Chisholm IH, Bird AC. Drusen as risk factors in age-related macular disease. Am. J. Ophthalmol. 1990;109:38-43. Available at: http://www.ncbi.nlm.nih.gov/pubmed/1688685. Accessed March 17, 2015.
11. Ferris FL, Davis MD, Clemons TE, et al. A simplified severity scale for age-related macular degeneration: AREDS Report No. 18. Arch. Ophthalmol. 2005;123:1570-1574.
12. Klein R, Klein BEK, Knudtson MD, Meuer SM, Swift M, Gangnon RE. Fifteen-year cumulative incidence of age-related macular degeneration: the Beaver Dam Eye Study. Ophthalmology 2007;114:253-262.
13. Rosenfeld PJ, Shapiro H, Tuomi L, Webster M, Elledge J, Blodi B. Characteristics of patients losing vision after 2 years of monthly dosing in the phase III ranibizumab clinical trials. Ophthalmology 2011;118:523-530.
14. Saint-Geniez M, Maharaj ASR, Walshe TE, et al. Endogenous VEGF is required for visual function: evidence for a survival role on müller cells and photoreceptors. PLoS One. 2008;3:e3554.
15. Nishijima K, Ng Y-S, Zhong L, et al. Vascular endothelial growth factor-A is a survival factor for retinal neurons and a critical neuroprotectant during the adaptive response to ischemic injury. Am. J. Pathol. 2007;171:53-67.
16. CATT Research Group: Martin DF, Maguire MG, Ying G, Grunwald JE, Fine SL, Jaffe GJ. Ranibizumab and bevacizumab for neovascular age-related macular degeneration. N. Engl. J. Med. 2011;364:1897-1908.
17. Chakravarthy U, Harding SP, Rogers CA, et al. Alternative treatments to inhibit VEGF in age-related choroidal neovascularisation: 2-year findings of the IVAN randomised controlled trial. Lancet 2013;382:1258-1267.
18. Busbee BG, Ho AC, Brown DM, et al. Twelve-month efficacy and safety of 0.5 mg or 2.0 mg ranibizumab in patients with subfoveal neovascular age-related macular degeneration. Ophthalmology. 2013;120:1046-1056.
19. Rofagha S, Bhisitkul RB, Boyer DS, Sadda SR, Zhang K. Seven-year outcomes in ranibizumab-treated patients in ANCHOR, MARINA, and HORIZON: a multicenter cohort study (SEVEN-UP). Ophthalmology. 2013;120:2292-2299.
2. Pascolini D, Mariotti SP. Global estimates of visual impairment: 2010. Br. J. Ophthalmol. 2012;96:614-618.
3. Friedman DS, O’Colmain BJ, Muñoz B, et al. Prevalence of age-related macular degeneration in the United States. Arch. Ophthalmol. 2004;122:564-72.
4. Rein DB, Wittenborn JS, Zhang X, Honeycutt AA, Lesesne SB, Saaddine J. Forecasting age-related macular degeneration through the year 2050: the potential impact of new treatments. Arch. Ophthalmol. 2009;127:533-540.
5. Bird AC, Bressler NM, Bressler SB, et al. An international classification and grading system for age-related maculopathy and age-related macular degeneration. The International ARM Epidemiological Study Group. Surv. Ophthalmol. 39:367-374. Available at: http://www.ncbi.nlm.nih.gov/pubmed/7604360. Accessed March 17, 2015.
6. Kawasaki R, Yasuda M, Song SJ, et al. The prevalence of age-related macular degeneration in Asians: a systematic review and meta-analysis. Ophthalmology 2010;117:921-927.
7. Krishnan T, Ravindran RD, Murthy GVS, et al. Prevalence of early and late age-related macular degeneration in India: the INDEYE study. Invest. Ophthalmol. Vis. Sci. 2010;51:701-707.
8. Klein R, Chou C-F, Klein BEK, Zhang X, Meuer SM, Saaddine JB. Prevalence of age-related macular degeneration in the US population. Arch. Ophthalmol. 2011;129:75-80.
9. Bressler SB, Maguire MG, Bressler NM, Fine SL. Relationship of drusen and abnormalities of the retinal pigment epithelium to the prognosis of neovascular macular degeneration. The Macular Photocoagulation Study Group. Arch. Ophthalmol. 1990;108:1442-1447. Available at: http://www.ncbi.nlm.nih.gov/pubmed/1699513. Accessed March 17, 2015.
10. Pauleikhoff D, Barondes MJ, Minassian D, Chisholm IH, Bird AC. Drusen as risk factors in age-related macular disease. Am. J. Ophthalmol. 1990;109:38-43. Available at: http://www.ncbi.nlm.nih.gov/pubmed/1688685. Accessed March 17, 2015.
11. Ferris FL, Davis MD, Clemons TE, et al. A simplified severity scale for age-related macular degeneration: AREDS Report No. 18. Arch. Ophthalmol. 2005;123:1570-1574.
12. Klein R, Klein BEK, Knudtson MD, Meuer SM, Swift M, Gangnon RE. Fifteen-year cumulative incidence of age-related macular degeneration: the Beaver Dam Eye Study. Ophthalmology 2007;114:253-262.
13. Rosenfeld PJ, Shapiro H, Tuomi L, Webster M, Elledge J, Blodi B. Characteristics of patients losing vision after 2 years of monthly dosing in the phase III ranibizumab clinical trials. Ophthalmology 2011;118:523-530.
14. Saint-Geniez M, Maharaj ASR, Walshe TE, et al. Endogenous VEGF is required for visual function: evidence for a survival role on müller cells and photoreceptors. PLoS One. 2008;3:e3554.
15. Nishijima K, Ng Y-S, Zhong L, et al. Vascular endothelial growth factor-A is a survival factor for retinal neurons and a critical neuroprotectant during the adaptive response to ischemic injury. Am. J. Pathol. 2007;171:53-67.
16. CATT Research Group: Martin DF, Maguire MG, Ying G, Grunwald JE, Fine SL, Jaffe GJ. Ranibizumab and bevacizumab for neovascular age-related macular degeneration. N. Engl. J. Med. 2011;364:1897-1908.
17. Chakravarthy U, Harding SP, Rogers CA, et al. Alternative treatments to inhibit VEGF in age-related choroidal neovascularisation: 2-year findings of the IVAN randomised controlled trial. Lancet 2013;382:1258-1267.
18. Busbee BG, Ho AC, Brown DM, et al. Twelve-month efficacy and safety of 0.5 mg or 2.0 mg ranibizumab in patients with subfoveal neovascular age-related macular degeneration. Ophthalmology. 2013;120:1046-1056.
19. Rofagha S, Bhisitkul RB, Boyer DS, Sadda SR, Zhang K. Seven-year outcomes in ranibizumab-treated patients in ANCHOR, MARINA, and HORIZON: a multicenter cohort study (SEVEN-UP). Ophthalmology. 2013;120:2292-2299.



